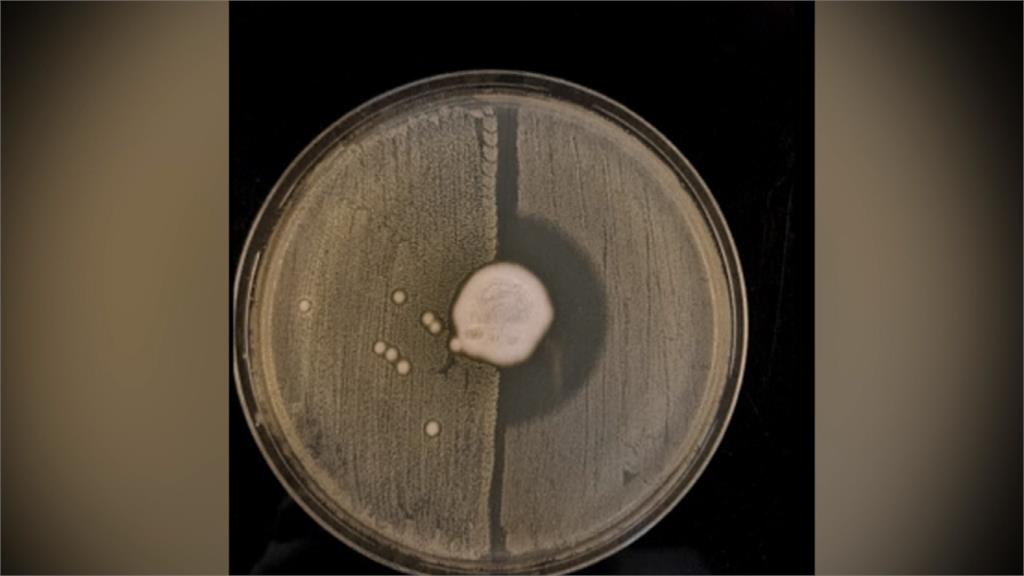

治療疾病時常會用到「抗生素」,普遍使用的青黴素就是其中一種,不過如果碰上對抗生素有強大耐性的超級細菌,抗生素就發揮不了作用。近期英國科學家就發現,刺猬身上普遍有著超級細菌存在,而原因和爭地盤有關,是自然演變的產物。
刺蝟寶寶瞇著眼,一臉享受地躺在手心上,讓主人梳理毛髮,這種小生物不僅可愛,現在還被發現是解開超級細菌、抗性之迷的關鍵。
研究共同作者荷姆斯指出:「我們是第一個證實,這種情況具體的在自然界發生,大約是在200年前。」
以往科學家認為,對青黴素類抗生素、具有強烈抗性的超級細菌,是20世紀中期人類過度使用抗生素而出現。不過英國劍橋大學近期發表的研究證實,其實超級細菌是自然演化的產物。
研究共同作者哈里森:「刺猬會被一種寄生真菌感染,有點像人類的癬,而這個會產生抗生素的真菌,與青黴素是同一家族。」
科學家發現,有兩種細菌長期在刺蝟身上爭地盤,一種是人畜共通的真菌「毛癬菌」,另一種就是有耐抗生素特性的金黃色葡萄球菌。
研究共同作者荷姆斯:「刺猬身上的毛癬菌產生抗生素時,一開始金黃色葡萄球菌,會直接被清除不是真菌對手,但它會獲得一個抗性基因。」
耐抗生素的金黃色葡萄球菌,從無數與毛癬菌的鬥爭中浴火重生,加強對抗生素的耐性,演變成現在的超級細菌。

科學家解釋,這項發現提醒人類,可能還有很多野生動物身上攜帶著超級細菌,不過也不用過度擔心,因為目前人畜共通的感染相對少見。
(民視新聞/曾若琦 綜合報導)



















